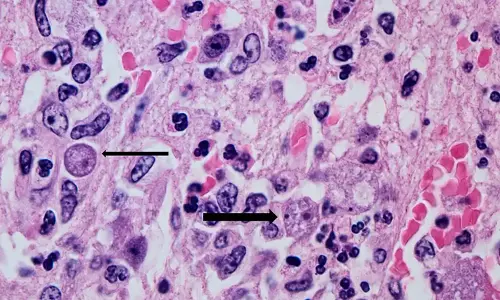
സംസ്ഥാനത്ത് ഒരാള്‍ക്ക് കൂടി അമീബിക് മസ്തിഷ്‌ക ജ്വരം

Recent Updates
''വോട്ട് കൊള്ളക്കാരില് നിന്ന് രാജ്യത്തെ വീണ്ടെടുക്കുക''...
22 Aug 2025 6:47 AM GMTയൂത്ത് കോണ്ഗ്രസ് പ്രസിഡന്റ് വില്പ്പനയ്ക്ക്, സ്ഥലം...
22 Aug 2025 6:22 AM GMTബോംബ് സ്ഫോടനം നടന്ന ആര്എസ്എസ് നിയന്ത്രണത്തിലുള്ള...
22 Aug 2025 6:13 AM GMT'തെരുവുനായ്ക്കളെ വന്ധ്യകരിച്ച ശേഷം വിട്ടയക്കാം'; ഉത്തരവ്...
22 Aug 2025 5:55 AM GMTകോഴിക്കോട്ട് ഭിന്നശേഷി കുട്ടികള് നടത്തുന്ന കട അടിച്ച്...
22 Aug 2025 5:45 AM GMTകാര്വാര് എംഎല്എ സതീഷ് കൃഷ്ണ സെയിലിന് ഇഡി നോട്ടീസ്; ചോദ്യം ...
22 Aug 2025 5:41 AM GMTപാലക്കാട്ട് ആദിവാസിയോട് ക്രൂരത; ആറു ദിവസം പട്ടിണിക്കിട്ട്...
22 Aug 2025 5:38 AM GMTഷാഫി പറമ്പില് നാടു വിട്ടോ?; ചോദ്യവുമായി മന്ത്രി വി...
22 Aug 2025 5:34 AM GMTനടുറോഡില് സുരേഷ് ഗോപി എം പിയുടെ മകന് മാധവ് സുരേഷും...
22 Aug 2025 5:33 AM GMT